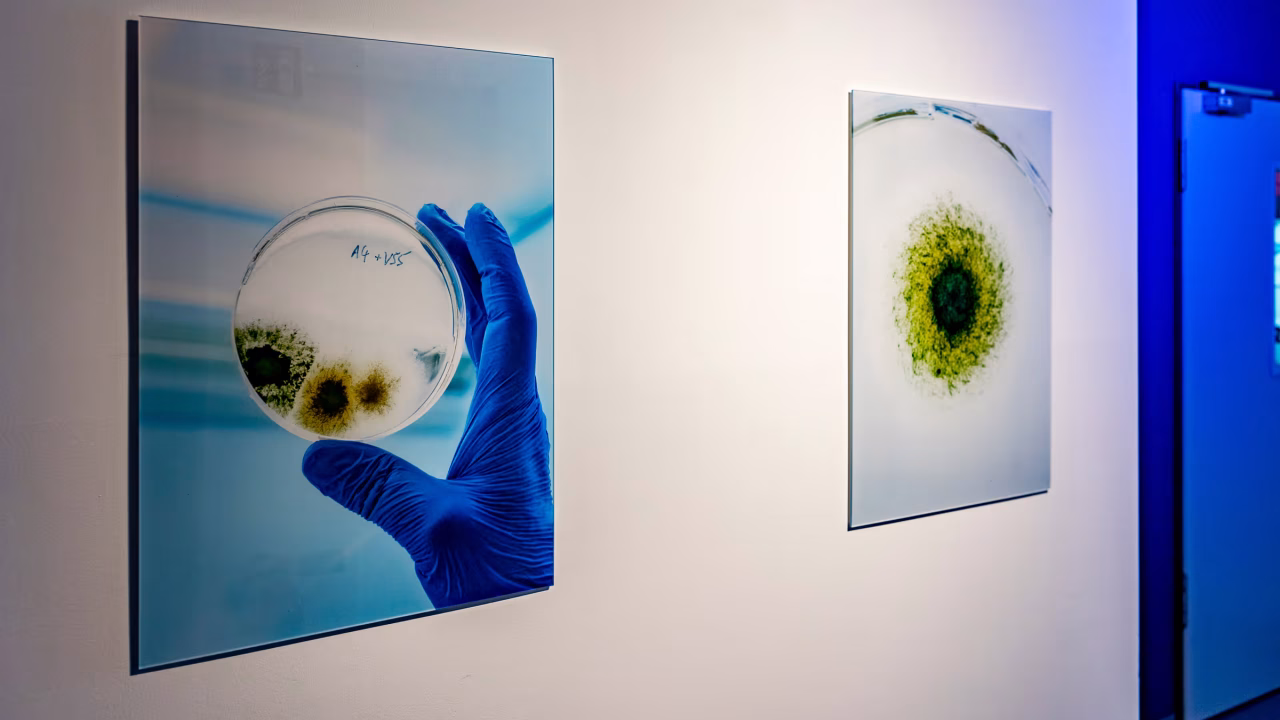
62b3d416aed68e11e36e7e6c_SLA_FORMO_grossaufnahmen_de-2-17

Formo is a pioneering food biotech company creating sustainable, animal-free dairy through precision fermentation. In 2021, Formo partnered with Smart Lab Architects to establish its new R&D lab and bioreactor pilot plant. Within just six months, we identified and transformed a 1,000 m² two-floor space into the “Formo Culture Campus” — a fully equipped, modern facility uniting their research and production teams under one roof.
600m² S1 R&D Lab
400m² Bioprocess Up- & Downstreaming
Frankfurt, DE
Completed
SLA provides an end-to-end service for projects, starting with understanding the workflow of our clients to handing over an operational facility.
Finding a move-in-ready Lab the size of Formo’s ambitions wasn’t easy, so we searched the real estate market and evaluated over 80 sites all across western Germany and even in the Netherlands.

With our automated monitoring tools, we found an amazing location in Frankfurt within a week that ticked all the boxes and that passed the rigorous due diligence checks we conducted with our expert partners.
A month later we had a signed rental contract and were ready to go.

This section contains temporary placeholder content.

This section contains temporary placeholder content.

In two months we designed the lab, planned all constructional changes, briefed the construction workers and zoned all lab rooms into an efficient layout, optimized for Formo’s workflows.
For the custom builds that really give the lab its unique feel, we’ve generated 3D renderings and detailed technical specifications.
Our goal in every Lab we design is to make it a place that the team identifies with and enjoys working in.
The Formo Lab is no exception to that human-centric design approach, so we designed every aspect down to the rooms’ signage to not only be efficient, but also visually appealing and in line with the Formo brand identity.
You can feel that this is a Formo Lab.

This section contains temporary placeholder content.

This section contains temporary placeholder content.

Although the new Formo building was in great condition, we restructured parts of the previous lab to create new spaces for the “Bioreactor Battle Station” — the heart of Formo’s precision fermentation pilot plant.

With support from our partners at Waldner and a team of specialists, we coordinated multiple construction companies digitally, using VR briefings to ensure precision, speed, and quality — completing the setup in just a few weeks instead of months.



Through our network of vendors, we procured a list of over 700 different consumables, machines, and other lab equipment items, managing more than a thousand requested positions in the process.

In a period of global supply chain interruptions, we are proud to have navigated most spontaneous manufacturer bottlenecks in days if not hours through the strength of these partnerships, showing the value of having great connections.


We coordinated the delivery and distribution of nearly 20 pallets of lab equipment, temporarily buffered in a specialized storage facility to ensure smooth logistics. In parallel, we organized the move of three full trailer truck loads from Formo’s previous lab to the new site, maintaining complete oversight of timing and handling.

To optimize costs and efficiency, we arranged CapEx-friendly financing options and facilitated discounts and deployments of professionally refurbished instruments. Additionally, we brokered pre-service testing (“Inbetriebnahme”) and ongoing maintenance contracts to guarantee that all systems were ready for immediate, reliable operation.

For a lab this size we’ve organized a two-week sprint to put all the pieces we’ve prepared in the previous months into place.
Together with the whole Formo team and many outstanding partners, we equipped the rooms with all kinds of lab machinery and consumables you need to create the future of food.

We installed smart lighting and multi-room sound, carried in the 100L bioreactor centerpiece, and upcycled its massive crate into a sunny terrace for lunches and after-work drinks—all while managing continuous shipments and equipment transfers from Formo’s previous lab.





Join us for a glimpse into our intense two-week Sprint, the constructions, deliveries and final touches all happening in parallel to finally lead to an operationally furnished lab.













